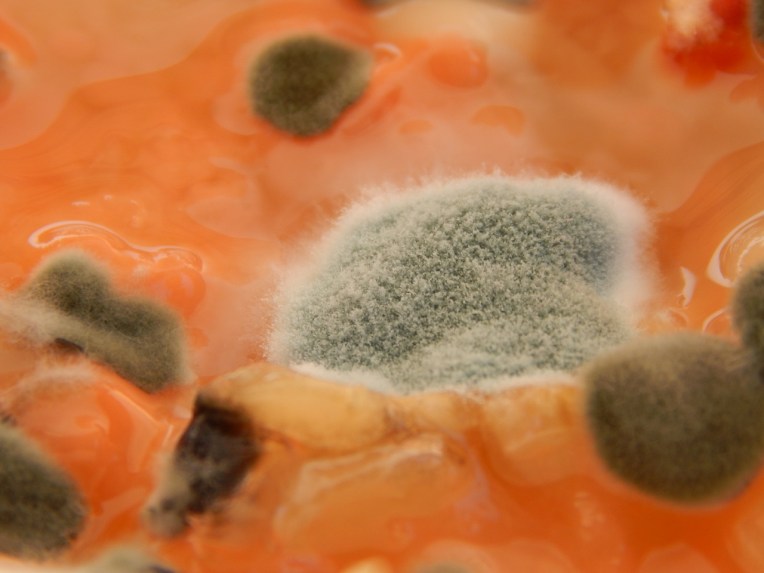
-Allison(sunset, balloon, mold) 038 (1280x960)
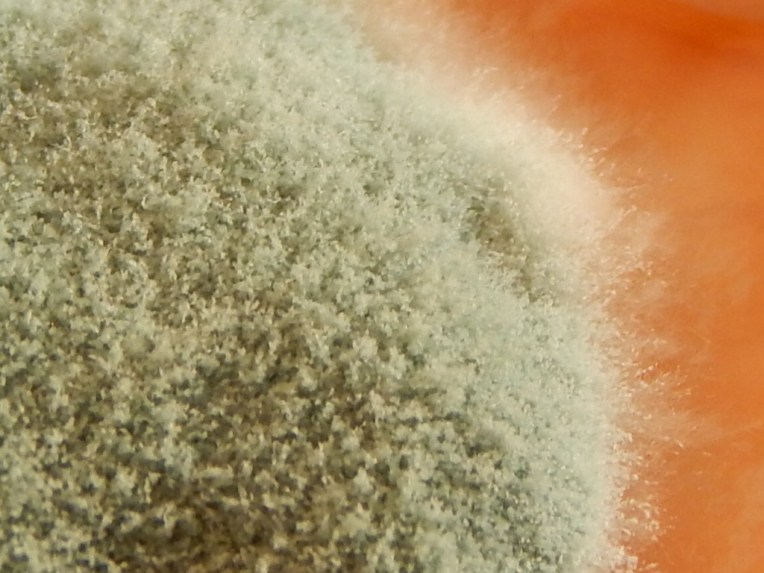
-Allison(sunset, balloon, mold) 046 (1024x768)
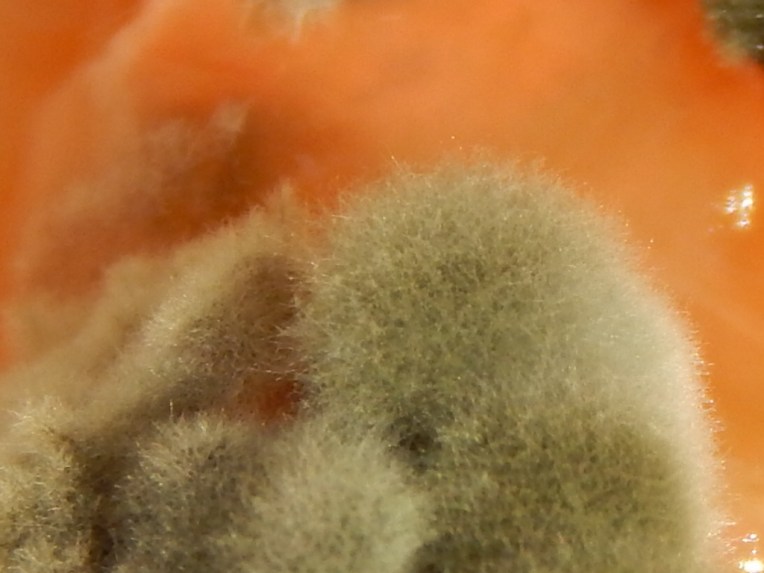
-Allison(sunset, balloon, mold) 037 (1024x768)

He-he. I’m doing a post about mold. I know it’s gross, but it’s also interesting, so bear with me! We were supposed to look at mold under the microscope for school, but before we did that, I took pictures (my camera is almost like a microscope it can take such close-up pictures). So now you know I didn’t just randomly pull some mold out of our fridge and take pictures of it – ’cause that’s what you were thinking, right? 🙂 😀 Okay, on to the pictures!

Ok, I’m done with the pictures, you can look now. Hey! I saw that face… 🙂 Well, it was your fault for reading this to begin with. But I’m sure glad you did read this, even if it was disgusting!
Thus ends a weird post about mold. Until later…
***Allison***

This was kinda gross….but also pretty cool and interesting! 😀
*Sunny
LikeLike
Thanks, Sunny! My sentiments exactly. 🙂
LikeLiked by 1 person
That’s so cool, but weird. Even though it’s gross, it still has a very important job!
LikeLike
Thanks for the comment, Rebekah!
LikeLike
Your welcome!
LikeLike
Haha, Mold is really amazing if you take time to look at it :). The second to last looks like a cookie!!
LikeLike
You’re right, Hayley! It does kind of look like a cookie… or some unidentified edible object. I don’t think it would taste as good as a cookie, though!
LikeLike
I’ll admit is… this was pretty gross…;) It was interesting at the same time, though! 🙂
LikeLike
Hee hee! Thanks, Clara.
LikeLiked by 1 person
Hehe! I like that mold that looks like a fuzzy pot of tar. 😉
LikeLike
I’m talking about the second to last one. 🙂
LikeLike
Gotcha.
LikeLike
Me too. I think that’s my favorite one!
LikeLike
ewww… But that’s really not that gross! 🙂 Hehe! Is it on Cantaloupe??? What ever the mold is on, it’s what looks gross to me!!!!!!!!!!!
~K.A.
LikeLike
Actually the mold is on spoiled pineapple. 🙂 Yep, the pineapple was pretty gross!
LikeLiked by 1 person
Hehe! I bet it wasn’t very tasty! 🙂
LikeLike
I didn’t try it, and I’m sure glad!
LikeLiked by 1 person
Ya! I bet you are! 🙂
LikeLike
By the way, there is a blog called lifesoabundant.wordpress.com ! The person-Megan-just got the blog! I’m the only one that has commented so far (I think) You should check it out! You’d like it, I bet!
LikeLike
OK, I’ll check it out! Thanks for the link, K. A.
LikeLiked by 1 person
Your welcome!!!
LikeLike
OH MY WORD. WHY.
LikeLike
You know, I wonder that myself.
LikeLike
:O
LikeLike